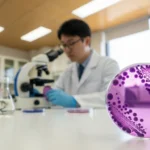
그람양성균

다래끼로 인해 운동에 제약이 생기셨나요? 다래끼가 났을 때 운동을 할 수 있는지 궁금하신가요? 이 글에서는 다래끼가 났을 때 안전하게 할 수 있는 운동과 주의사항을 소개합니다.
다래끼 운동
다래끼는 눈 주위에 염증이 발생하면서 통증과 붓기를 동반하는 증상입니다. 많은 사람들은 다래끼가 발생하면 운동을 피해야 한다고 생각하지만, 사실 적절한 운동을 통해 빠른 회복을 도울 수 있습니다. 다만, 다래끼가 났을 때는 눈에 부담을 주지 않는 운동을 선택하는 것이 중요합니다.
다래끼 운동의 특징
-
가벼운 유산소 운동
다래끼가 생겼을 때 가장 중요한 점은 눈에 과도한 압력을 주지 않는 것입니다. 가벼운 유산소 운동, 예를 들어 걷기나 자전거 타기와 같은 운동은 눈에 부담을 주지 않으면서 혈액순환을 돕습니다. -
스트레칭
다래끼를 치료하는 동안 스트레칭은 매우 유익합니다. 스트레칭을 통해 몸의 긴장을 풀고, 전반적인 혈액 순환을 도울 수 있습니다. 눈 주위 근육에 직접적인 자극을 주지 않기 때문에 안심하고 할 수 있습니다. -
심호흡 운동
다래끼가 생겼을 때 스트레스가 심해지기도 하는데, 심호흡 운동은 몸과 마음의 긴장을 풀어줍니다. 이 운동은 눈과 관련된 압박을 증가시키지 않기 때문에 안전하게 할 수 있습니다.
다래끼 운동의 장점
-
혈액 순환 촉진 다래끼 치료 중에도 적절한 운동을 하면 혈액 순환이 좋아져 염증이 더 빨리 회복될 수 있습니다.
-
스트레스 해소 운동은 스트레스를 해소하고, 심리적인 안정감을 주어 다래끼 회복에 긍정적인 영향을 미칩니다.
-
몸의 피로 완화 장시간의 휴식 후 운동을 하면 몸의 피로를 풀어주는 데 도움을 줍니다.
다래끼가 나았을 때 운동을 하는 것이 전혀 위험하지 않지만, 반드시 주의가 필요합니다. 다래끼가 심각하게 번지지 않도록 눈 주위에 과도한 자극을 주지 않도록 하세요.
다래끼 났을 때 운동
다래끼가 난 상태에서는 운동을 할 수 있는지에 대해 걱정하는 사람들이 많습니다. 사실 다래끼는 눈에 염증을 일으키는 질환이기 때문에 운동 중 눈에 직접적인 충격이 가지 않도록 주의해야 합니다. 그러나 눈 주위에 과도한 자극을 주지 않는 운동을 통해 회복을 도울 수 있습니다.
다래끼 났을 때 추천하는 운동
-
걷기
걷기는 다래끼가 났을 때 가장 안전한 운동 중 하나입니다. 눈에 전혀 자극을 주지 않으며, 가볍게 혈액 순환을 촉진시킬 수 있습니다. -
수영 (눈에 물이 들어가지 않게 주의)
다래끼가 심하지 않다면 수영도 가능합니다. 다만, 물이 눈에 들어가지 않도록 주의해야 합니다. 눈에 물이 들어가면 감염이 악화될 수 있기 때문입니다. -
가벼운 요가
요가는 스트레칭과 심호흡을 함께 할 수 있어 다래끼로 인한 스트레스를 줄여줄 수 있습니다. 다만, 몸을 과도하게 구부리거나 눈에 자극을 줄 수 있는 자세는 피하는 것이 좋습니다.
다래끼 났을 때 운동 시 주의사항
-
눈에 자극을 주지 말 것 운동 중 눈에 자극을 주지 않도록 각별히 신경 써야 합니다.
-
과도한 체력 소모 피하기 지나치게 강한 운동은 다래끼 회복에 방해가 될 수 있습니다. 가벼운 운동을 통해 몸 상태를 유지하는 것이 중요합니다.
-
상태에 맞는 운동 선택 다래끼의 상태에 따라 운동 강도를 조절해야 합니다. 증상이 심할 때는 운동을 피하는 것이 좋습니다.
다래끼가 났을 때 운동을 통해 몸의 회복을 도울 수 있지만, 무리한 운동은 상태를 악화시킬 수 있으므로 주의가 필요합니다.
다래끼 헬스
다래끼가 생겼을 때 헬스장 운동을 하는 것은 다소 도전적일 수 있습니다. 헬스장에서 고강도의 운동은 눈에 부담을 줄 수 있으므로, 다래끼가 있을 때는 운동 강도를 줄이고, 눈에 자극을 주지 않는 운동을 선택하는 것이 중요합니다.
다래끼 헬스 운동 추천
-
자전거 타기
헬스장에서 자전거 타기는 무릎과 허벅지 근육을 강화하면서도 눈에 부담을 주지 않는 유산소 운동입니다. 페달을 굴리며 심박수를 올리고, 다래끼로 인한 전반적인 피로를 줄일 수 있습니다. -
체중 운동
체중을 이용한 운동은 다래끼 회복에 큰 무리가 가지 않으며, 간단히 할 수 있습니다. 스쿼트나 푸시업과 같은 운동은 근육을 강화하면서도 눈에 자극을 주지 않습니다. -
가벼운 덤벨 운동
덤벨을 이용한 운동은 무거운 웨이트를 사용하지 않고도 전신 운동을 할 수 있습니다. 하지만 눈에 과도한 부담을 주지 않도록 조심히 해야 합니다.
다래끼 헬스 운동 시 유의사항
-
눈에 자극을 주는 운동 피하기 헬스장에서 눈에 과도한 자극을 줄 수 있는 운동, 예를 들어 너무 빠르게 달리기나 고강도 훈련은 피하는 것이 좋습니다.
-
운동 후 적절한 휴식 다래끼가 있을 때 운동 후에는 충분한 휴식을 취해야 합니다. 눈에 피로가 쌓이지 않도록 해야 합니다.
-
위생 관리 철저히 헬스장에서 운동 후 눈을 자주 만지지 않도록 하고, 손 세정을 철저히 하여 감염을 예방해야 합니다.
운동을 할 때는 반드시 다래끼 상태를 고려한 운동을 선택하고, 눈에 무리가 가지 않도록 조절해야 합니다.
결론
다래끼가 났을 때 운동을 하는 것이 불가능한 것은 아닙니다. 중요한 것은 눈에 자극을 주지 않도록 하며, 가벼운 유산소 운동이나 스트레칭과 같은 활동을 선택하는 것입니다. 다래끼 회복을 돕는 운동은 혈액 순환을 촉진시키고, 스트레스를 줄이며, 전반적인 체력을 유지하는 데 유익합니다. 그러나 운동을 할 때는 다래끼의 상태에 맞게 강도를 조절하고, 눈에 부담을 주지 않는 운동을 선택하는 것이 중요합니다.